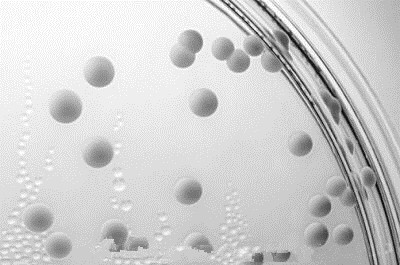

在我们肉眼看不见的微观世界,生活着各种各样的微生物,尽管它们大多拥有比人类更长的历史,但我们从真正见识到它们距今却只有三百多年历史——1673年,荷兰一个热爱科学的门卫,用自己发明的显微镜,把多年来观察到的记录交给了英国皇家学会,现代医学才拉开了微生物研究的序幕。
在这之前的数千年,人类对感染性疾病的真正原因其实一无所知,不同的传统医学有不同的理论解释,但都是归于臆测,没有实证基础;我们最熟悉的,当然就是五花八门的各种湿、热、毒、瘴…了。其中对于念珠菌在女性阴道內增殖引起的瘙痒、充血、分泌物变化现象,旧医就把它归为肝肾阴虚、湿毒蕴结、脾虚湿热等原因。找出真正的病因在医学上非常重要,它将揭示疾病的本质,并直接影响治疗方法。
念珠菌是一种单细胞酵母菌,外观呈圆球形,广泛存在于人体和环境中。在人体里它们主要生长在那些与外界相通的器官中,尤其是酸性的阴道。
它们与其它真菌、细菌形成的菌群互相抗衡,通常相安无事。只有在特殊情况下,出现了特别适宜念珠菌生长的条件和/或不适宜其它菌群生长的条件,念珠菌大量生长并扩张势力,菌群平衡被打破,才会导致人体生病。所以我们也把念珠菌称为条件致病菌;成为致病菌后的念珠菌,通常会从芽生孢子的外观变为为长条形菌丝。

被念珠菌感染所致的阴道炎,称为念珠菌阴道炎(VVC)。

女性的阴道环境适宜念珠菌生存,大约75%健康女性一生至少会得一次念珠菌阴道炎,45-50%为两次以上。相对来说,健康男性则较少发病,但其与患念珠菌阴道炎(VVC)的妇女性接触感染率也可达69.4%。
—-
什么原因会导致阴道内念珠菌大量生长呢?常见有:
1.妊娠。妊娠期性激素水平升高,可使阴道上皮细胞内糖原含量增加,降低了阴道内环境的PH值,有利于念珠菌生长。
2.糖尿病控制不佳。糖代谢异常可令糖原在阴道上皮内的含量增加,降低了PH值。
3.长期应用糖皮质激素。糖皮质激素可通过促进糖原异生导致阴道上皮糖原含量升高,PH值降低。激素导致局部免疫功能受损,也易被念珠菌感染。
4.长期/先前有应用抗生素。特别是广谱抗生素,可通过抑制念珠菌的对抗菌种间接促进念珠菌生长。
5.性传播。虽然内源性感染是主要致病途径,但外源性感染亦不少见。健康妇女与健康男性性接触感染率约32%,但与患念珠菌龟头炎的男性性接触感染率可达80%。
—-
妇检涂片或进行培养及其它实验检查出念珠菌就需要治疗吗?
绝大多数情况并不需要。前面说过了,念珠菌是条件致病菌,只要不导致感染症状,它们就是人体的正常菌群,无需赶尽杀绝。治疗的指征主要取决于是否出现感染症状,常见有:
1.瘙痒。
2.外阴潮红,伴出现点/片状鲜红糜烂面。
3.白带增稠、增多,呈豆腐渣样,有恶臭味(细菌性多为鱼腥样气味)。
4.自觉瘙痒、灼热。
例外的、无症状也建议治疗的情况:患者免疫功能低下,如ICU中的器官移植、造血干细胞移植术后患者,发生侵袭性真菌病(IFD)的风险升高,只要检查发现长有菌丝的致病性念珠菌,就需治疗。
—-
VVC的治疗有什么关键?为什么的人很容易治好,有的人很难治好?
偶发的轻-中度感染,多由白色念珠菌引起,称为单纯型VVC,占患病人数的80-90%,足够疗程的局部治疗或口服药就能解决问题。
另有10-20%的患者,发病原因不明,致病菌也较复杂(非白色念珠菌),多为重度感染,一般抗真菌药无效,一年内发病四次或以上的,称为复杂型VVC。治疗方案需包括7~14天的初始治疗和6个月的巩固治疗。但即使这样,仍有30~50%的患者会复发。
—-
感染了VVC,性伴需同时治疗吗?
单纯型VVC通常并非性接触传染,不推荐常规对性伴同时治疗。但对复杂型VVC及性伴出现念珠菌龟头炎的可予治疗。
—-
治疗VVC的常药物有哪些?
1.多烯类:
两性霉素B阴道泡腾片(妊娠B,哺乳L3)
2.吡咯类:
氟康唑(口服,妊娠C/D,哺乳L2)
伊曲康唑(口服,妊娠C,哺乳L2)
1~2%克霉唑栓/霜(OTC,妊娠B/C,哺乳L1)
2~5%咪康唑霜/栓(OTC,妊娠C,哺乳L2)
0.4~0.8%特康唑霜/栓(妊娠C,哺乳L3)
3.丙烯类:
特比奈芬阴道泡腾片(妊娠B,哺乳L2)
注意:几种局部外用的唑类抗真菌药均可在整个孕期使用,但口服药不用于治疗妊娠期急性VVC。(CDC 2010)
—-
乳酸菌对念珠菌阴道炎作用吗?
没有。正常状态下,阴道内厌氧菌与需氧菌的比例为5∶1,二者处于平衡状态。乳酸菌就是阴道内一种重要的的厌氧菌,可分解糖类物质生成大量乳酸,降低阴道内的PH值,抑制其它有害的细菌增长。但念珠菌同样具有强发酸能力,可在乳酸菌分解糖原时发挥协同作用,它们之间有明显的战略互惠关系,制造的酸性环境利于双方生长,在医学上属于共生性菌种。
—-
综上,我们可以得知,预防VVC的方法是尽量避免诱发因素,措施包括减肥、控制血糖、低GI饮食与合理锻炼配合、不滥用抗生素及激素、不滥用乳酸菌治疗阴道感染。大部分VVC与性传播的关系很小,不必因此对性伴侣的忠诚过多怀疑。出现不适及时就医,明确诊断并规范用药。VVC虽然发病率高,但大多数情况并不难治。
—-
部分参考文献:
杜静平等.阴道微生态失调状态的研究.中国微生物杂志,2002,14(4):192-193
IDSA:念珠菌临床实验指南.Clin Infect Dis.2009 Mar 1;48(5):503-35
中华医学会.2011念珠菌病诊断与治疗:专家共识
2010美国疾病控制中心阴道炎治疗指南
注:部分图片来源于网络。
(本文转载自健康中国人网)